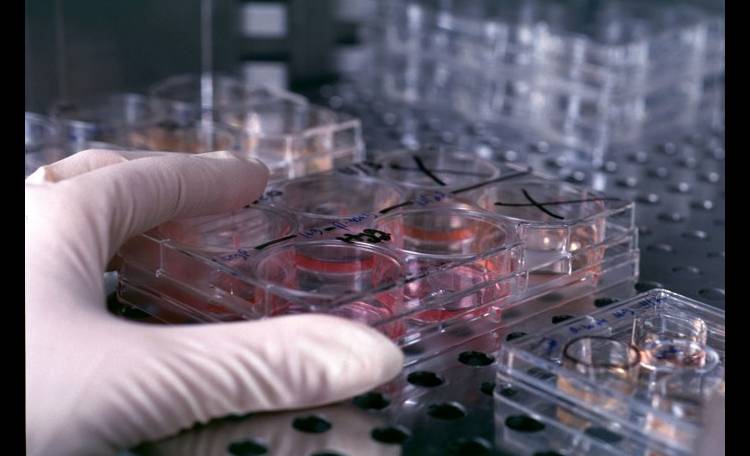
Cellule staminali

Il team internazionale coordinato dall’Istituto di genetica e biofisica “Buzzati-Traverso” del Consiglio nazionale delle ricerche (Igb-Cnr) di Napoli ha scoperto che i meccanismi cellulari sono coinvolti nello sviluppo del cancro, in particolare ha evidenziato il ruolo fondamentale di vitamine e aminoacidi. Lo studio è stato pubblicato sulla rivista Stem Cell Reports ed è il risultato di un lavoro coordinato con gli Istituti Cnr di chimica biomolecolari, di applicazione del calcolo dell’Università Olandese Nijmegen e dell’Università della California.
Gabriella Minchiotti, ricercatrice autrice dello studio ha spiegato: “Abbiamo scoperto con sorpresa che nelle cellule staminali un ruolo chiave è svolto da due insospettabili attori denominati ‘metaboliti’ (molecole molto piccole indispensabili per la vita della cellula) che corrispondono alla Vitamina C e all’aminoacido L-Prolina. Abbiamo dimostrato che le cellule staminali embrionali pluripotenti (ossia cellule staminali presenti nei primissimi stadi dello sviluppo), se trattate con Vitamina C acquisiscono uno stato più immaturo (primitivo), mentre se trattate con l’aminoacido L-Prolina danno luogo alla formazione di una cellula embrionale più matura (stato cosiddetto primed). Quindi Vitamina C e L-Prolina agiscono in maniera del tutto opposta sulle cellule staminali embrionali, determinando delle modifiche al DNA che non ne alterano la sequenza bensì il modo in cui viene letto e quindi la sua attività”. Prosegue sulle cellule staminali: “Le cellule staminali embrionali sono le più ‘potenti’ perché sono le uniche in grado di dare origine a tutti i tipi di cellule che si trovano in un organismo come le cellule ossee, cardiache eccetera. Questa caratteristica è propria anche delle cellule staminali tumorali che sostengono la crescita del tumore”, campo di interesse molto rilevante per i ricercatori poiché queste possiedono la capacità di rinnovarsi da sole e differenziarsi.
La ricercatrice ha poi concluso: “I risultati raggiunti rappresentano un grande passo in avanti nella ricerca perché, attraverso la regolazione dei metaboliti possiamo inibire o attivare i meccanismi che determinano la crescita e il destino delle cellule staminali embrionali e in futuro anche di quelle tumorali”.












